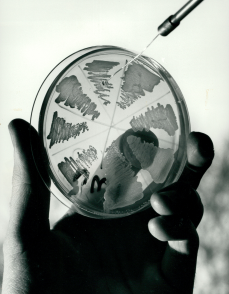
gsk.com

The world desperately needs new antibiotics to get ahead of the growing threat of pathogens – disease-causing organisms. However, in the face of unique scientific and financial hurdles, the number of potential drugs in the pipeline has dwindled. Despite these difficulties, some companies, including GSK, are pressing ahead, hoping to revive the field and take on one of the biggest health challenges facing humanity.
Antibiotics were one of the most significant medical discoveries of the 20th century. Before their widespread use in the 1940s, human suffering from bacterial infections was enormous. Infections, from tuberculosis to pneumonia, led to serious illness and sometimes death, while 90% of children with bacterial meningitis died.
The introduction of antibiotics extended people’s lives by an estimated 20 years. But if these medicines stop working, routine surgeries and cancer treatments, which can weaken the body’s ability to respond to infections, would become too risky. Common illnesses and minor injuries could be more complex, costly, and more challenging to treat.
Resistance to antibiotics occurs naturally as bacteria evolve to evade drugs that would normally kill them or stop their growth. However, the widespread use and misuse of treatments in humans, animals and crops has accelerated the process of bacterial evolution that leads to antibiotic resistance.
The situation is already alarming. A report in The Lancet in 2024 estimated drug-resistant bacterial infections directly caused 1.14 million deaths in 2021, about 15% of which were in children under five.
While the rising risk of AMR has become more urgent, progress towards implementing tangible initiatives to address the issue has been patchy.
“Many people, including politicians, now know what AMR is in a way they didn’t a decade ago,” says Sally Davies, the UK special envoy on AMR and England’s former Chief Medical Officer.
“The problem is there are many and multiplying issues to address. But I’m saying, `You’ve actually got another pandemic going on.’ It’s insidious and it’s getting worse.”
In 2013, Davies warned that drug-resistant superbugs posed a “catastrophic threat”, and urged global leaders to take action. She also paid a visit to then UK Prime Minister David Cameron and called for an independent review to assess the risks.
Cameron heeded the warning. The resulting report (PDF - 2.3MB) that he commissioned came to a troubling conclusion: drug resistance, if left unchecked, could have a significant cost to society, both in terms of number of lives lost and economic damage. Recent estimates suggest that almost 40 million lives could have been lost by 2050 and the additional costs to health systems globally could reach $159 billion per year.
“Covid was like a tsunami,” says Robert Bowers, who led antibiotic commercialisation at GSK at the time. “It hit massively. It hit violently, and it washed over the world, but it will pass.
“AMR is like rising sea levels. It will keep rising. It will not stop, and suddenly we’ll be standing there with water around our knees.”

A medical revolution
Penicillin revolutionised the field of medicine. GSK legacy companies played important roles in the research and manufacture of the drug in the late 1930s.
By 1944, Glaxo produced about 80% of the UK’s penicillin doses through its Greenford site, helping to solve a problem that plagued the WW2 battlefields – the wait time between a soldier being wounded and getting to see a doctor. In the Allied Forces, this was almost 14 hours. Administering penicillin to the wound in the interim vastly increased chances of survival before surgery.
In 1945, Beecham Group established their research arm, Beecham Research Laboratories, with a focus on antibiotics. Twelve years later, their scientists discovered the penicillin nucleus – the core of the molecule, known as 6-APA. From this nucleus they determined they could develop new, even more effective penicillin.
History of antibiotics
Over the following decades, antibiotics have helped reduce deaths from infectious diseases by more than 70% and have continued to play a crucial role in making surgeries much safer. However, in recent years, the discovery of new drugs has slowed to a crawl – and bacterial resistance has increased apace.
As a result, many of the big players have pulled out of antibiotic production, and smaller companies have gone bust. What’s more, the limited number of new antibiotics discovered since the 1980s are largely variations of older drugs.
Still in the hunt
Despite the daunting odds, and driven by the urgent need to tackle AMR, some companies are forging ahead. GSK remains in the hunt around 80 years after its first efforts to produce penicillin during World War II. Now, more than a dozen R&D projects at the company could help target pathogens deemed critical or urgent by the WHO.
These projects include vaccines, which are also an important part of the solution. Of the top six bacterial pathogens responsible for AMR deaths, only one – Streptococcus pneumonia – has a vaccine, the WHO said in 2022.
Companies are exploring multiple technologies to fight pathogens such as Pseudomonas aeruginosa and Klebsiella pneumoniae, and next generation vaccines for Streptococcus pneumonia. GSK’s Multiple Antigen Presenting System technology, or MAPS technology, is part of this toolbox.
A primary target for GSK is urinary tract infections (UTIs), which affect about half of women and one in 20 men during their lifetimes. One of the most common outpatient infections, uncomplicated UTIs are becoming increasingly resistant to antibiotics.
Scientists are relying on a new approach that blocks two key enzymes that enable bacterial cells to replicate their DNA. In current antibiotics used to treat UTIs through these enzymes, only a single mutation is needed to cause resistance, says Neil Osheroff, a professor of biochemistry and medicine at Vanderbilt University. His team specialise in examining the mechanism of early-stage antibiotics.
With the new approach, researchers are hoping to gain an edge.
“This novel mechanism means that new antibiotics should defeat resistant pathogens that have mechanisms that currently protect them from other antibiotics,” Osheroff says.
The work is part of a broader race to find novel antibiotics before infections become untreatable. A WHO analysis published in 2022 estimated that only 27 experimental antibiotics were under development against priority pathogens. Of those, just six fulfilled at least one of the WHO’s innovation criteria and two would be able to target highly-drug resistant forms of bacteria.
“Time is running out,” Osheroff continues. “New drug classes are incredibly important to extend the clock.”
Partnering with others on a mission to tackle AMR is key to GSK’s antibiotics strategy.
BioVersys, a Swiss pharmaceutical company taking aim at the highest priority pathogens, is one of GSK’s collaborators. The company has received funding from the $1 billion AMR Action Fund – a powerful alliance of stakeholders investing in antibiotic development. Some of the focus is also shifting to phage therapy, which relies on naturally occurring, bacteria-killing viruses known as bacteriophages, says Henry Skinner, the fund’s chief executive officer.
Keeping the antibiotics pipeline afloat isn’t the only challenge for the fund, Skinner adds. There’s another problem: replacing all the scientists who have left the field after their projects faltered and likely won’t return.
“We’re losing the human talent,” Skinner says. “That’s one of the biggest risks in the intermediate term.”

Coordinated action
A shake up in the way governments around the world pay for antibiotics is also critical to tackling AMR, says Kevin Outterson, executive director at CARB-X – a Boston-based nonprofit which also invests in antibiotic developers such as BioVersys and more than 90 others.
“We mobilised significantly, and for good reason, on HIV and malaria,” Outterson says. “We have global institutions spending billions to try to bring those diseases to zero, but we’re arguing about spending a tenth of that on AMR, a threat that kills more people today than HIV or malaria.”
But policy makers are already taking some positive steps to rekindle investment, he adds.
A pioneering program in the UK is providing developers with a fixed annual fee regardless of how much, or how little, of their drugs are used, basing payments on the value of the drugs to the health system rather than the volumes used. Proposed legislation in the US also calls for a subscription-style model that would give companies upfront payments in exchange for access to antibiotics. Other governments plan their own measures to change the way they pay for antibiotics.
In May 2024, GSK became the first founding partners of the Fleming Initiative, a collaborative approach led by Imperial College Healthcare NHS Trust and Imperial College London to tackle antimicrobial resistance (AMR) around the world. The company made a £45 million pledge available for approved projects to harness new technology including AI to better interpret and use complex scientific data, identify new opportunities to develop novel treatments and interventions, improve understanding of how drug-resistant infections are transmitted and can be prevented, and more.
Getting a novel antibiotic or two across the finish line and making it a commercial success could provide a spark for the industry as it waits for government policies to encourage research and development, says GSK’s Bowers.
“People need a success to prove that this can be done,” Bowers says. “Otherwise, the sea levels are going to keep rising, and no one will take this on.”
Davies, whose efforts helped pave the way for a 2016 United Nations declaration to combat AMR, is keeping up the momentum.
She played a leading role in raising awareness and corralling UN Member States to agree on targets for reducing deaths associated with AMR in the 2024 United Nations declaration.
“We need to be bold again,” she says.
This article was first published in April 2023